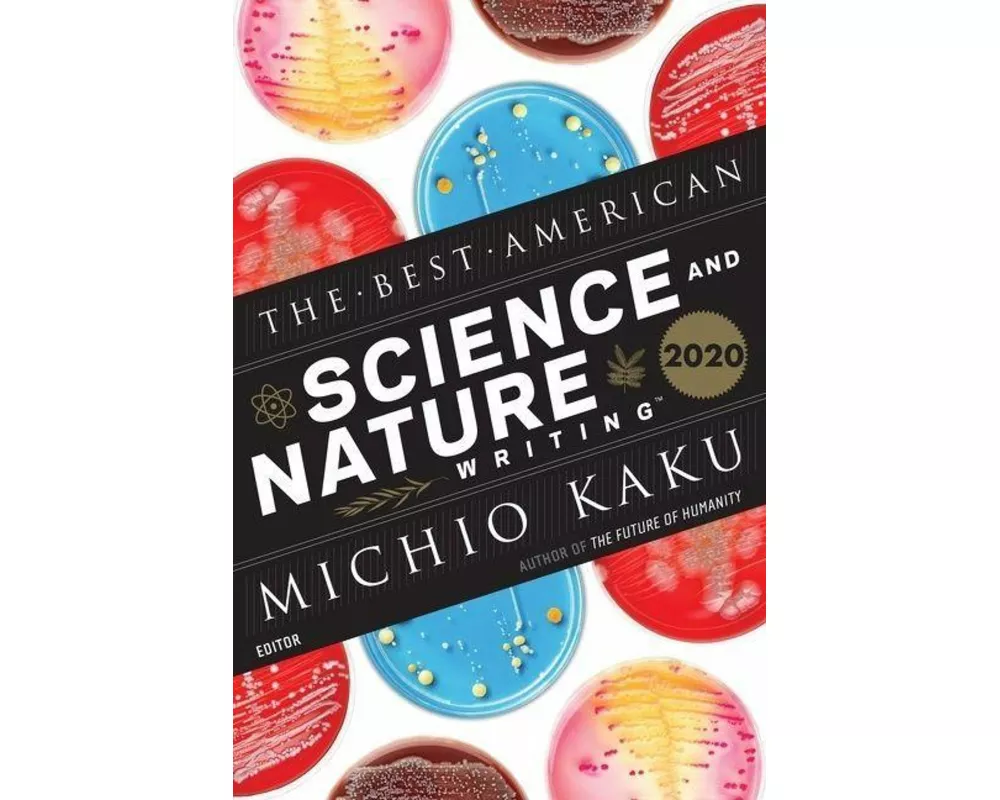
The Best American Science and Nature Writing 2020

Marke: Houghton Mifflin Harcourt
Hier finden Sie zu den besten Preisen alle Produkte der Marke Houghton Mifflin Harcourt.
Bestellungen bis 17:00 Uhr für Produkte auf Lager erhalten Sie - ohne Versandgebühr - am nächsten Werktag.
2
Meistgekauft
Auf Lager:
1
The Best American Science and Nature Writing 2020
CHF 30.–
3
Meistgekauft
Auf Lager:
1
The Vanderbeekers and the Hidden Garden
CHF 20.10
4
Auf Lager:
1
Playing Atari with Saddam Hussein
Based on a True Story
CHF 20.10